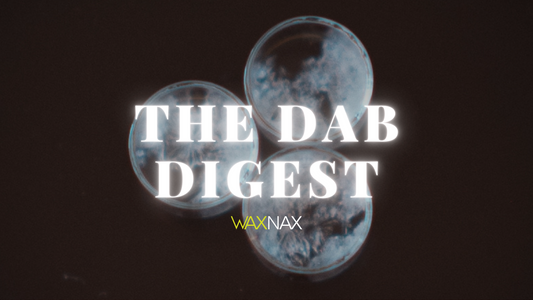
The Dab Digest #15

Blog

Cold Start Dabbing Method
Welcome back to another edition of The Dab Digest! Today, we're talking cold start dabbing, a technique that's gaining popularity for its simplicity and ability to provide a smoother and...
Cold Start Dabbing Method
Welcome back to another edition of The Dab Digest! Today, we're talking cold start dabbing, a technique that's gaining popularity for its simplicity and ability to provide a smoother and...
Exploring THCa and CBDa for Recovery and Inflam...
Welcome back to another edition of the Dab Digest by WaxNax! Today, we're diving deep into the world of acidic cannabinoids, particularly THCa and CBDa. If you're new to the...
Exploring THCa and CBDa for Recovery and Inflam...
Welcome back to another edition of the Dab Digest by WaxNax! Today, we're diving deep into the world of acidic cannabinoids, particularly THCa and CBDa. If you're new to the...

Traveling with Dabs the Art of Discreetness
Welcome to the 13th edition of The Dab Digest. Today we are talking about traveling with your dabs and the challenges presented. From juggling multiple one gram jars to carrying...
Traveling with Dabs the Art of Discreetness
Welcome to the 13th edition of The Dab Digest. Today we are talking about traveling with your dabs and the challenges presented. From juggling multiple one gram jars to carrying...

Decoding Different Dab Consistencies and How to...
Welcome back to another edition of The Dab Digest! Today, we are diving into the world of dabbing and explore the variety of dab consistencies. Whether you're a seasoned dabber...
Decoding Different Dab Consistencies and How to...
Welcome back to another edition of The Dab Digest! Today, we are diving into the world of dabbing and explore the variety of dab consistencies. Whether you're a seasoned dabber...

Elevate Your Brand with WaxNax Travel Kits!
Greetings, dab enthusiasts! We're thrilled to bring you this week's edition of The Dab Digest, where we explore exciting ways to take your brand, dispensary, or event to new heights....
Elevate Your Brand with WaxNax Travel Kits!
Greetings, dab enthusiasts! We're thrilled to bring you this week's edition of The Dab Digest, where we explore exciting ways to take your brand, dispensary, or event to new heights....

The Rise of Portable Dabbing Devices
Welcome back to another exciting edition of The Dab Digest, your go-to source for all things dabbing! In this week's edition, we're diving into the ever-growing world of portable dabbing...
The Rise of Portable Dabbing Devices
Welcome back to another exciting edition of The Dab Digest, your go-to source for all things dabbing! In this week's edition, we're diving into the ever-growing world of portable dabbing...
